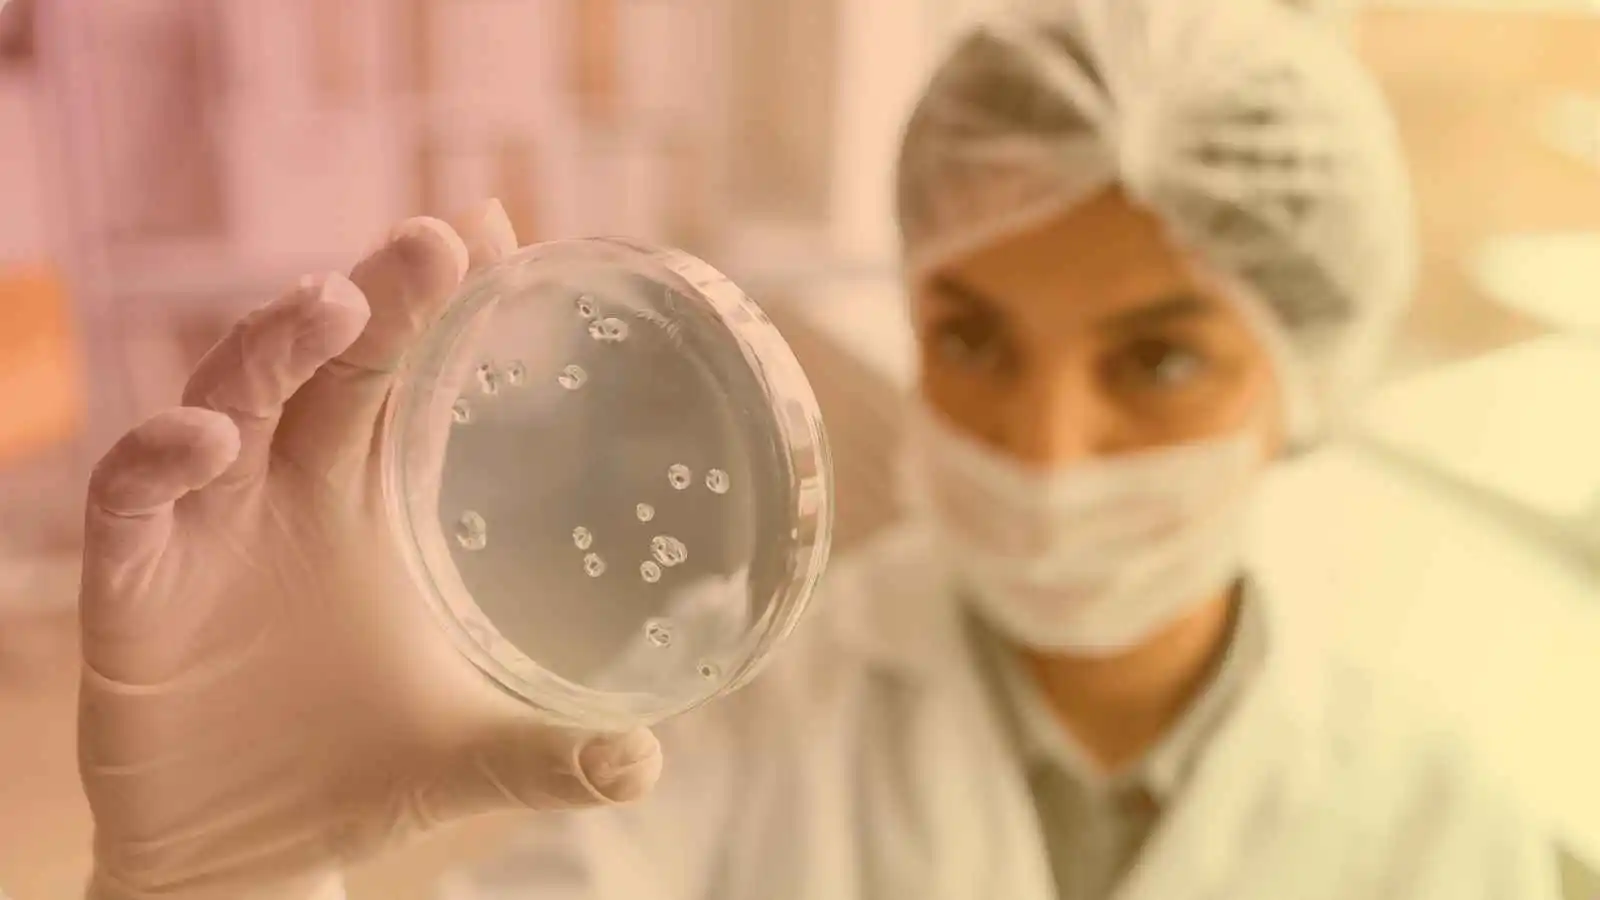
Cough

Cough
Cough is most frequent symptom of respiratory disease. It is caused by stimulation of sensory nerves in the mucosa of pharynx, larynx, trachea & bronchi Sputum production is common in both acute or chronic cough
Causes
- There are numerous viral and bacterial agents
- Adenovirus
- Measles, chickenpox
- Group A streptococcus
- Croup (barking cough), whooping cough
- Influenza or mononucleosis
Role of Homoeopathy
Homoeopathic medicine helps to decreases irritation of bronchial mucosa & thus recurrence of cough stops. If cough is of chronic nature, then these homoeopathic remedies will cure the basic causes of cough & slowly but surely repetition & intensity of cough get decreased. Homoeopathic remedies are selected on the basis of characteristic of cough e.g dry, rattling, loud sound; along with that on basis of color & consistency of sputum is also there. So there are different remedies for different type of cough. It helps to prevent future pathological derangement in lungs from prolong cough.
Remedies
- Antimonium tartaricum
- Drosera
- Hepar sulphuris
- Spongia
- Phosphorus